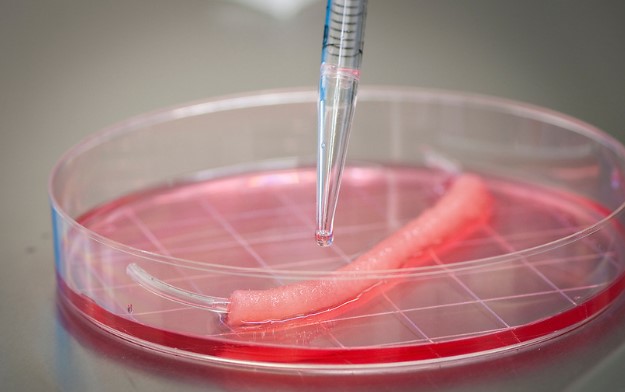
Regenerative Medicine Breakthrough

Milestones of Caring
North Carolina Baptist Hospital began as a place of healing and teaching. From one century to the next, we have helped shape health care in North Carolina and beyond.
Today, Atrium Health Wake Forest Baptist Medical Center is part of Advocate Health, the fifth-largest health system in the country, and is a thriving, nationally renowned academic learning health system.
The health system is the largest employer in northwest North Carolina, with more than 22,000 employees. It is licensed for 1,535 acute care, psychiatric and rehabilitation beds and operates four community hospitals, and more than 300 primary and specialty care outpatient clinics.
Over the years, the original hospital has grown to include 100 buildings on 290 acres, including a 196-acre research farm, a downtown innovation district and school of medicine, with a second medical school campus under construction in Charlotte, N.C.
Explore some of the milestones that have made us a nationally recognized academic learning health system right here in Winston-Salem.
Through the Years
1923
 North Carolina Baptist Hospital Opens
North Carolina Baptist Hospital Opens
On May 28, 1923, North Carolina Baptist Hospital opened its five-story, 88-bed hospital. The goal was to provide medical care to the Winston-Salem community and educate future doctors, nurses and other medical professionals.
Old Main was the original Baptist Hospital building. On October 24, 1978, the building was demolished to make room for Watlington Hall.
First Baby Born
The first baby born on the day the hospital opened was Fred Trivette. The bill for his mother's 16-day hospital stay was $76.85 plus $1 extra for the baby's ID necklace. Fred grew up to be an N.C. highway patrol officer.
 School of Nursing Opens
School of Nursing Opens
The School of Nursing opened in July of 1923 and educated nurses until 1974. Today, alumni continue to support nurses through generous scholarship funds.
1928
 Progressive Care Building Completed
Progressive Care Building Completed
Completed in 1928, the Progressive Care Building is the oldest remaining building on campus today. It was once the Blanche Barrus Nurses’ Home, where nursing students lived while studying at North Carolina Baptist Hospital. It is located at the corner of Hawthorne Road and Medical Center Boulevard.
1940
 Construction Begins on the Medical School
Construction Begins on the Medical School
Upon his death, Bowman Gray Sr. left money for a “charitable endeavor” to help the people of Winston-Salem and the surrounding region. The money came from the success of R.J. Reynolds Tobacco Co., where Gray served as president and chairman. His brother, wife and two sons donated it to a medical school willing to relocate to Winston-Salem.
Wake Forest College, then located in Wake Forest, N.C., agreed to move its two-year medical school and expand it to a four-year curriculum, partnering with North Carolina Baptist Hospital.
1941
Medical School Cornerstone Laid
The cornerstone of the Bowman Gray School of Medicine was laid on April 16, 1941. The school opened with 75 new, first-year students and 30 second-year students. The first class graduated in 1943.
1942
Hospital Adds Education Programs
Between 1942 and 1944, Baptist Hospital added training programs for dietitians, nurse anesthetists, and X-ray and medical technologists.
1943
 First MD Class
First MD Class
The first graduating class of Bowman Gray School of Medicine physicians.
 Nurses Train in Accelerated Military Program
Nurses Train in Accelerated Military Program
Nurses participated in accelerated training during World War II. Of the 122 who applied, 115 were accepted, received uniforms, and salaries of $15-20 a month. The hospital received tuition reimbursement and nurses agreed to remain in military or civilian nursing during the war.
1944
 First Female Medical Student
First Female Medical Student
Dr. Jean Bailey Brooks was the only female in the School of Medicine’s Class of 1944. She was also the first female president of the Medical Alumni Association.
1945
 Dr. Lucile Hutaff First Female Faculty Member
Dr. Lucile Hutaff First Female Faculty Member
In 1945, Dr. Lucile Hutaff joined the faculty at the Bowman Gray School of Medicine. She later became the first woman to hold the rank of full professor and was named Emeritus Professor of Community Medicine in 1972.
1946
 Graylyn Estate Gift
Graylyn Estate Gift
Nathalie Fontaine Gray and her sons gifted the Graylyn estate to Wake Forest’s Bowman Gray School of Medicine, along with $60,000 to remodel the building to be used as a rehabilitation and convalescent center. The manor has 60 rooms and 46,000 square feet on an 87-acre plot of land. The original cost was $3 million.
 Outpatient Department Opens
Outpatient Department Opens
The Outpatient Department was built in a two-story, 19,000 square foot facility next to the Nurse's Home and Old Main. People who needed medical care but could not afford it came to the Outpatient Department. In 1947, 26,691 patients visited the facility, and record high numbers of patients came each year after that. Patients came from more than 88 counties in North Carolina and several states.
The Outpatient Department also served as a teaching facility for the School of Nursing and School of Medicine for several specialty clinics. The building was demolished in 1978 along with Old Main to make room for Watlington Hall.
1947
 School of Pastoral Care Opens
School of Pastoral Care Opens
The School of Pastoral Care opened in Bowman Gray School of Medicine. Here students were trained to provide spiritual support for families and patients during and after treatment.
Today, the Department of FaithHealth Education’s CPE Program provides fully accredited education to carry on that mission.
 Graylyn Used as Psychiatric Facility
Graylyn Used as Psychiatric Facility
Four services were included on the grounds of Graylyn to provide psychiatric care: Graylyn School for Exceptional Children in Amos Cottage, (shown); Pediatric Development Clinic; Center for Psychology, Reading and Speech; and the Children’s Center for Handicapped.
1950
Doctors Defy Segregation
Some Black patients were provided care at North Carolina Baptist Hospital despite segregation of hospitals. Clinical faculty often classified Black patients as Lumbee Native Americans to bypass segregation rules.
1954
 South Wing Expansion
South Wing Expansion
The South Wing of Baptist Hospital opened with an expansion of beds for private patients. The institution was financially stable with more than 15,000 admissions and more than 120,000 patients.
1955
First Radiology Training Program for MD Students
Dr. Isadore Meschan, who was known for developing innovative teaching methods, created the first radiology training program for medical students in the U.S. He believed radiographic imaging was a vital way for students to learn about the anatomy.
1956
 Cancer Treatment Innovation
Cancer Treatment Innovation
The School of Medicine and Baptist Hospital was the first in North Carolina to use cobalt to treat cancer patients.
 Davis Memorial Chapel Built
Davis Memorial Chapel Built
Built in Baptist Hospital in honor of Egbert L. Davis Sr., the first chairman of the North Carolina Baptist Hospital Board of Trustees, and in memory of his wife, Annie Pearl Shore Davis.
Davis Memorial Chapel has strategically placed symbols in the ceiling panels, stained glass windows, carvings and everything else in between. On the altar, the intricate woodwork design of clustered oaks signifies strength and longevity; the acorns, birth and regeneration.
 Hospital Expands Education Again
Hospital Expands Education Again
Baptist hospital developed separate schools in medical technology, cytotechnology, X-ray technology, nurse anesthesia, medical records librarians, practical nursing and pastoral counseling. Here is a photo of nurse anesthetists from 1959.
1959
 First Native American MD Student Graduates
First Native American MD Student Graduates
Dr. James G. “Jim” Jones, a Lumbee Indian who grew up in Pembroke, N.C., became the first Native American MD student to graduate from Bowman Gray School of Medicine.
 James A. Gray Memorial Building Opens
James A. Gray Memorial Building Opens
The School of Medicine dedicated the James A. Gray Memorial Building in honor of the school’s 20th anniversary. The building doubled the square footage of the School of Medicine.
Today, the Gray building houses the Coy C. Carpenter Library, research labs and offices.
1961
 Progressive Care Center Receives National Attention
Progressive Care Center Receives National Attention
The Progressive Care Center received national attention when it was remodeled to take care of hospital patients who did not need full-time nursing care.
1964
 First Hand Reattachment in U.S.
First Hand Reattachment in U.S.
Dr. Jesse Meredith performed the first hand reattachment in the U.S. on patient Robert Pennell, who had his left hand severed by a brush axe.
Desegregation of Medical School and Hospital
The hospital and the medical school adopted desegregation policies in education, employment and patient care.
1967
 Computer System Grant
Computer System Grant
A $984,000 medical school grant from the National Institutes of Health (NIH) allowed for a computer system to be installed that provided physicians much needed medical information in minutes, which improved patient care.
 William Grimes
William Grimes
William Grimes became the first Black medical student at the School of Medicine and graduated in 1972.
 Dr. William Quivers
Dr. William Quivers
Dr. William Quivers was the first full-time Black faculty member and served as a professor of pediatrics. Read about more Barrier Breakers.
 First Male Nursing Student
First Male Nursing Student
Jon Kent Stockham became the first male nursing student at the School of Nursing.
1968
 Kidney Stone Removal
Kidney Stone Removal
Dr. William Boyce invented the first non-invasive, kidney stone removal process using ice. In the early 1980s, Dr. Boyce used the typical “Taylor Slushy-Ice” machine but with different ingredients to remove difficult kidney stones. The kidney was frozen or placed in a hypothermic state and clamped off in a cold temperature to cause a minimal amount of bleeding during the stone removal.
1969
 Cancer Detection
Cancer Detection
The hospital became the first in the U.S. to use ultrasound to detect prostate cancer.
 Hanes Building Opens
Hanes Building Opens
Named in honor of the Hanes family, the Hanes Building allowed for more medical student enrollment and space for laboratories.
1970
 Abdominal Organ Transplant Program
Abdominal Organ Transplant Program
The Medical Center established the Abdominal Organ Transplant Program. To date, surgeons have performed around 5,000 kidney and pancreas transplants. This is the largest program in North Carolina and one of the busiest in the Southeast.
1972
 First Black Nursing Student
First Black Nursing Student
Fernanda Gordon became the first Black nursing student at the School of Nursing.
1974
 Last Nursing Class
Last Nursing Class
The last class of diploma nursing students graduated in 1974. The School of Nursing program was phased out at the Medical Center with the graduating class of 85 senior nursing students. Today, Wake Forest University School of Medicine’s Department of Academic Nursing offers doctoral nursing degrees in Nurse Anesthesia (CRNA) and Doctor of Nursing Practice.
First Black Nursing Director
 Gwen Andrews became the first Black nursing director and served in that role until 1988. Read more about other Barrier Breakers.
Gwen Andrews became the first Black nursing director and served in that role until 1988. Read more about other Barrier Breakers.
CAT Scanner
 In July 1974, the first computerized axial tomography (CAT) scanner in North Carolina was installed in the radiology department at Wake Forest Baptist Medical Center.
In July 1974, the first computerized axial tomography (CAT) scanner in North Carolina was installed in the radiology department at Wake Forest Baptist Medical Center.
1975
 First Black MD Graduate
First Black MD Graduate
Dr. Yvonne J. Weaver became the first Black medical student graduate. Read more about other Barrier Breakers.
1980
 Home Away from Home
Home Away from Home
In honor of their 3-year-old son who died from leukemia, Penny and Dick Latham, started the “Rainbow House.” This “home away from home” was for families of children who were seriously ill. The current facility is now known as Ronald McDonald House and includes 35 bedrooms with private baths.
 Burn Center
Burn Center
The Burn Unit opened at North Carolina Baptist Hospital in 1980. Today, the Burn Center is one of only two in North Carolina.
1981
 Brenner Center for Adolescent Medicine
Brenner Center for Adolescent Medicine
The Brenner Center for Adolescent Medicine opened. As the first program of its kind in North Carolina and one of only 26 in the nation, it provided patient care and training of students and physicians to treat teenagers.
1982
Level I Trauma Center
The medical center became – and continues to be - the only Level I Trauma Center in western North Carolina. As a Level I Trauma Center, care teams provide total care for every aspect of injury – from prevention through rehabilitation.
1983
 Transcranial Doppler Ultrasound
Transcranial Doppler Ultrasound
The Medical Center was the first in the U.S. to use transcranial Doppler ultrasound to diagnose and treat plaque buildup on the walls of the carotid artery and to take images of the arterial circulation in the brain. Dr. William M. McKinney, who started at the School of Medicine as a neurology intern, pioneered the technique and developed the term neurosonology.
 First MRI in North Carolina
First MRI in North Carolina
A Magnetic Resonance Imaging (MRI) system was installed in 1983, the first in North Carolina at an academic medical center.
1986
Baptist AirCare
 North Carolina Baptist Hospital established AirCare, a 24/7 helicopter emergency medical service. Neonatal transport service began in 1987. Today, helicopters are located at three sites across the region with critical care ambulances at affiliated hospitals.
North Carolina Baptist Hospital established AirCare, a 24/7 helicopter emergency medical service. Neonatal transport service began in 1987. Today, helicopters are located at three sites across the region with critical care ambulances at affiliated hospitals.
First Heart Transplant
 The first heart transplant at North Carolina Baptist Hospital was successfully performed on 17-year-old Jeffrey Richardson.
The first heart transplant at North Carolina Baptist Hospital was successfully performed on 17-year-old Jeffrey Richardson.
Brenner Children’s Hospital and Health Service
 Brenner Children’s Hospital and Health Service was established in 1986, through a generous gift from the Brenner family. Brenner Children’s is the only children’s hospital in northwest North Carolina.
Brenner Children’s Hospital and Health Service was established in 1986, through a generous gift from the Brenner family. Brenner Children’s is the only children’s hospital in northwest North Carolina.
Noninvasive Gallstone Treatment
 Medical Center urologists were the first in the U.S. to use lithotripsy successfully to break up gallstones in the common duct. Extracorporeal shockwave lithotripsy (ESWL) dramatically changed the management of renal and ureteral calculus disease, better known as “stones.” With ESWL, stones are pulverized into smaller fragments by shockwaves and can then pass spontaneously as small fragments. ESWL is noninvasive, requires less anesthesia than other treatments for renal stones, and helps patients avoid surgical intervention or endoscopic procedures.
Medical Center urologists were the first in the U.S. to use lithotripsy successfully to break up gallstones in the common duct. Extracorporeal shockwave lithotripsy (ESWL) dramatically changed the management of renal and ureteral calculus disease, better known as “stones.” With ESWL, stones are pulverized into smaller fragments by shockwaves and can then pass spontaneously as small fragments. ESWL is noninvasive, requires less anesthesia than other treatments for renal stones, and helps patients avoid surgical intervention or endoscopic procedures.
1987
 Brenner Infant Transport
Brenner Infant Transport
Brenner Children’s Hospital infant transport began as one of the largest neonatal/pediatric transport systems in the U.S. Operating 24 hours a day, seven days a week, the infant transporting ambulance was like a mini-intensive care nursery equipped with transport incubators, heart monitors, ventilators and pumps. Each vehicle carried two “transporters,” a registered nurse and respiratory therapist. They traveled by ambulance or helicopter to community hospitals in a 20-county region to stabilize premature or sick infants and bring them to Brenner’s neonatal or pediatric intensive care nurseries.
1989
Bone Marrow Transplant Program Established
The hospital established the Bone Marrow Transplant program.
 Single-Lung Transplant
Single-Lung Transplant
Medical Center surgeons performed the first single-lung transplant in North Carolina. Bill Anderson was hired at the School of Medicine as supervisor of organ acquisitions, part of Surgery Research in the Hanes Building.
1990
Wound VAC Invented
Vacuum-Assisted Closure (VAC), the “wound vac” was invented by Drs. Louis Argenta and Michael Morykwas. This negative pressure wound therapy was successfully used on a patient in 1993 and became a major, life-saving device that is now used worldwide to treat large wounds.
Blocked Artery Innovation
Medical Center cardiologists became the first in North Carolina to successfully open a blocked artery using a laser.
 Brain Surgery Innovation
Brain Surgery Innovation
The Medical Center became the first in the Carolinas to treat tumors and abnormal blood vessel deep within the brain by using stereotactic radiosurgery. This minimally-invasive process was so precise that it destroyed the tumor or vessel problem without harming surrounding tissue, and patients usually returned home the same day.
1992
 Double Organ Transplant
Double Organ Transplant
Dr. Michael Rohr performed the first double organ transplant at North Carolina Baptist Hospital when Pam Brown received both a new kidney and pancreas.
1997
Center on Aging & Rehabilitation
 The J. Paul Sticht Center on Aging and Rehabilitation opened, and became the first facility in the world to incorporate geriatric acute care, transitional care, psychiatry and rehabilitation under one roof.
The J. Paul Sticht Center on Aging and Rehabilitation opened, and became the first facility in the world to incorporate geriatric acute care, transitional care, psychiatry and rehabilitation under one roof.
1999
Two World-First MRI Uses
The Medical Center was the first in the world to report the successful use of magnetic resonance imaging (MRI) to diagnose significant blockages in blood vessels leading to the heart. Later that year, researchers were the first to use MRI to view the heart during vigorous beating and diagnose blocked arteries.
 North Carolina’s First Gamma Knife
North Carolina’s First Gamma Knife
The Medical Center installed the first and only Gamma Knife in North Carolina. The Gamma Knife is an alternative to traditional brain surgery.
2000
Forensic Nurse Examiner Program
The Medical Center established a Forensic Nurse Examiner Program within its Emergency Department to treat victims of domestic violence, sexual assault and child abuse.
 Downtown Health Plaza Opens
Downtown Health Plaza Opens
Downtown Health Plaza opened to provide primary and specialty care to families, along with other resources and support services at low cost.
2001
New Brain Tumor Treatment
 Physicians at Wake Forest Baptist Medical Center were the first in the world to treat a brain tumor patient with the newly FDA-approved GliaSite Radiation Therapy System, a balloon catheter device for the delivery of brachytherapy in brain cancer patients.
Physicians at Wake Forest Baptist Medical Center were the first in the world to treat a brain tumor patient with the newly FDA-approved GliaSite Radiation Therapy System, a balloon catheter device for the delivery of brachytherapy in brain cancer patients.
2003
Chromosome Discovery
Wake Forest Baptist Medical Center researchers were the first to report that unidentified genes on chromosomes 18 and 3 are linked to severe kidney damage in younger Black people with diabetes.
2004
 Comprehensive Cancer Center
Comprehensive Cancer Center
The Comprehensive Cancer Center opened in 2004, with a six-story addition in 2013. This facility includes both outpatient and inpatient cancer care. As a National Cancer Institute-designated Comprehensive Cancer Center, the care provided is in the top 5% nationwide.
2006
Regenerative Medicine Breakthrough
Regenerative Medicine Breakthrough
The Wake Forest Institute for Regenerative Medicine was the first in world to grow an organ in a laboratory that was successfully implanted into a human.
2008
Partnership to Address Pediatric Trauma
 In 2008, NASCAR Hall of Famer, Richard Childress, and his family partnered with Wake Forest Baptist Medical Center and Drs. Charlie Branch and Wayne Meredith to launch the Childress Institute for Pediatric Trauma. The mission of the Institute is to discover and share the best ways to prevent and treat severe injuries in children. Today, it is led by Dr. John Petty.
In 2008, NASCAR Hall of Famer, Richard Childress, and his family partnered with Wake Forest Baptist Medical Center and Drs. Charlie Branch and Wayne Meredith to launch the Childress Institute for Pediatric Trauma. The mission of the Institute is to discover and share the best ways to prevent and treat severe injuries in children. Today, it is led by Dr. John Petty.
Wake Forest Baptist is now also home to the Safe Kids Northwest Piedmont coalition.
2008 -2018
Community Hospitals
Wake Forest Baptist added four community hospitals to expand care throughout the region: Lexington Medical Center in 2008, Davie Medical Center and Wilkes Medical Center in 2017, and High Point Medical Center in 2018.
2010
Falls Assessment Program
J. Paul Sticht Center on Aging implemented Falls Assessment program by pairing MD students with healthy volunteers from Meals on Wheels in Forsyth County to help homebound older adults.
2011
 Level 1 Pediatric Trauma Center
Level 1 Pediatric Trauma Center
Brenner Children’s Hospital opened the first Level l Pediatric Trauma Center in North Carolina. The new, state-of-the-art pediatric emergency department also opened. The pediatric trauma center and pediatric emergency department are the only ones in the area.
2012
BioTech Place
 Wake Forest Biotech Place, a world-class research building, opened in Piedmont Triad Research Park, another milestone in development of the pioneering downtown park.
Wake Forest Biotech Place, a world-class research building, opened in Piedmont Triad Research Park, another milestone in development of the pioneering downtown park.
Today, Innovation Quarter is anchored by Wake Forest University School of Medicine and is home to a community of more than 4,500 workers in 115 companies and four other institutions of higher learning.
2013
Comprehensive Stroke Center
The Medical Center became one of 33 medical centers nationwide to be certified as a Comprehensive Stroke Center by The Joint Commission.
CRNA Program Received Prestigious Accreditation
The Nurse Anesthesia program was the first in the U.S. and second in the world to be accredited by the International Federation of Nurse Anesthetists.
2014
 Heart Surgery Alternative
Heart Surgery Alternative
Wake Forest Baptist cardiac surgeons were the first in North Carolina to perform a less-invasive aortic valve replacement procedure called transcaval valve replacement.
Office of Cancer Health Equity Opened
The Office of Cancer Health Equity (OCHE) opened to advance community engagement, clinical care and research to ensure the best cancer care possible for everyone in our communities.
2016
 Wake Forest School of Medicine Opened in New Location
Wake Forest School of Medicine Opened in New Location
The Wake Forest School of Medicine opened the Bowman Gray Center for Medical Education, in downtown Winston-Salem's Innovation Quarter.
2017
First Female CEO and Dean
 Dr. Julie Ann Freischlag became the first female CEO of Wake Forest Baptist Medical Center and, in 2018, the first female Dean of Wake Forest School of Medicine.
Dr. Julie Ann Freischlag became the first female CEO of Wake Forest Baptist Medical Center and, in 2018, the first female Dean of Wake Forest School of Medicine.
2019
The Birth Center and Dale and Karen Sisel NICU Opened
 The Birth Center opened at Wake Forest Baptist Medical Center, bringing a new level of convenience, comfort and patient- and family-centered care. The Dale and Karen Sisel Neonatal Intensive Care Unit (NICU) also opened at Brenner Children’s Hospital, featuring state-of-the-art technology and all-private rooms.
The Birth Center opened at Wake Forest Baptist Medical Center, bringing a new level of convenience, comfort and patient- and family-centered care. The Dale and Karen Sisel Neonatal Intensive Care Unit (NICU) also opened at Brenner Children’s Hospital, featuring state-of-the-art technology and all-private rooms.
Mobile Health Program Launched
 In 2019, Wake Forest Baptist and the Community Health Alliance (CHA), created the mobile health program to bring health care to underserved neighborhoods and schools.
In 2019, Wake Forest Baptist and the Community Health Alliance (CHA), created the mobile health program to bring health care to underserved neighborhoods and schools.
Today, the mobile health program is a service of Atrium Health’s Department of Community Health. It is staffed by nurse practitioners, a certified medical assistant and a social worker who collaborate with community organizations, including homeless shelters, faith communities, and other easily accessible community locations, to provide medical, nursing, preventive and nutrition services.
2020
 COVID-19 Pandemic
COVID-19 Pandemic
The COVID-19 pandemic became the deadliest disease outbreak in recent American history, surpassing the estimated deaths of the 1918 flu. The medical center quickly responded in many ways to keep patients, staff and the community safe. Our physician-scientists tested the effectiveness of various mask designs, led research studies to measure community transmission, helped develop vaccines and designed face masks that were distributed across the community.
Dr. Katherine Poehling served on the prestigious CDC Advisory Committee on Immunization Practices (ACIP). She and her colleagues examined research and data and provided advice and guidance to the CDC director regarding the use of vaccines in the U.S.
Dr. Christopher Ohl hosted regular updates that were streamed live, providing encouragement and timely information to those in the community, across the country and around the world.
In December, the medical center was the first in North Carolina, and one of the first in the U.S., to receive the Pfizer COVID-19 vaccine. Employees began receiving vaccinations, and in early 2021, the health system began offering the vaccine to older patients. Once vaccines became more widely available, the health system used a variety of innovative tactics to offer vaccinations to those who were most vulnerable, and partnered with FEMA and public health agencies to hold vaccination events and ensure everyone had access, particularly those who lived in underserved communities.
As the emergency use authorization for the Pfizer COVID-19 vaccine was expanded to include adolescents, and later children, Brenner Children’s began offering the vaccine.
Best Care for All
Wake Forest Baptist Health, Wake Forest School of Medicine and Atrium Health united to improve health, elevate hope and advance healing - for all
2022
Critical Care Tower Groundbreaking
 Ground was broken for a $450 million critical care tower at the medical center. The investment in this world class facility will transform emergency and critical care throughout the region.
Ground was broken for a $450 million critical care tower at the medical center. The investment in this world class facility will transform emergency and critical care throughout the region.
Reimagining Health Care
Wake Forest University School of Medicine became the academic core of Advocate Health, the fifth-largest non-profit integrated health system in the U.S., which was created through the combination of Atrium Health and Advocate Aurora Health.
2023
 First Black School of Medicine Dean
First Black School of Medicine Dean
Dr. L. Ebony Boulware joined Wake Forest University School of Medicine as the first Black Dean, and the Vice Chief Academic Officer and Chief Science Officer of Advocate Health. Dr. Boulware is leading the development of a second School of Medicine campus in Charlotte, promoting growth as an inclusive organization, and educating the next generation of health care leaders.
Health Equity Partnership
Atrium Health Wake Forest Baptist will serve as the medical partner for the Metropolitan Village mixed-use redevelopment project being built in East Winston-Salem. The Maya Angelou Center for Health Equity will be relocated here to establish a health equity center in the heart of East Winston-Salem, and Wake Forest Baptist will have space for health and wellness coaching and nurse navigators who will work directly with residents on their goals and needs.
 Second School of Medicine Campus Groundbreaking
Second School of Medicine Campus Groundbreaking
Wake Forest University School of Medicina and Atrium Health broke ground on a regional campus for the School of Medicine in Charlotte, N.C. The 20-acre site, located in midtown Charlotte, will anchor The Pearl, the innovation district that will help reshape and diversify the economy of the region, integrating research, clinical expertise, entrepreneurial activity, corporate engagement and community inclusion.
